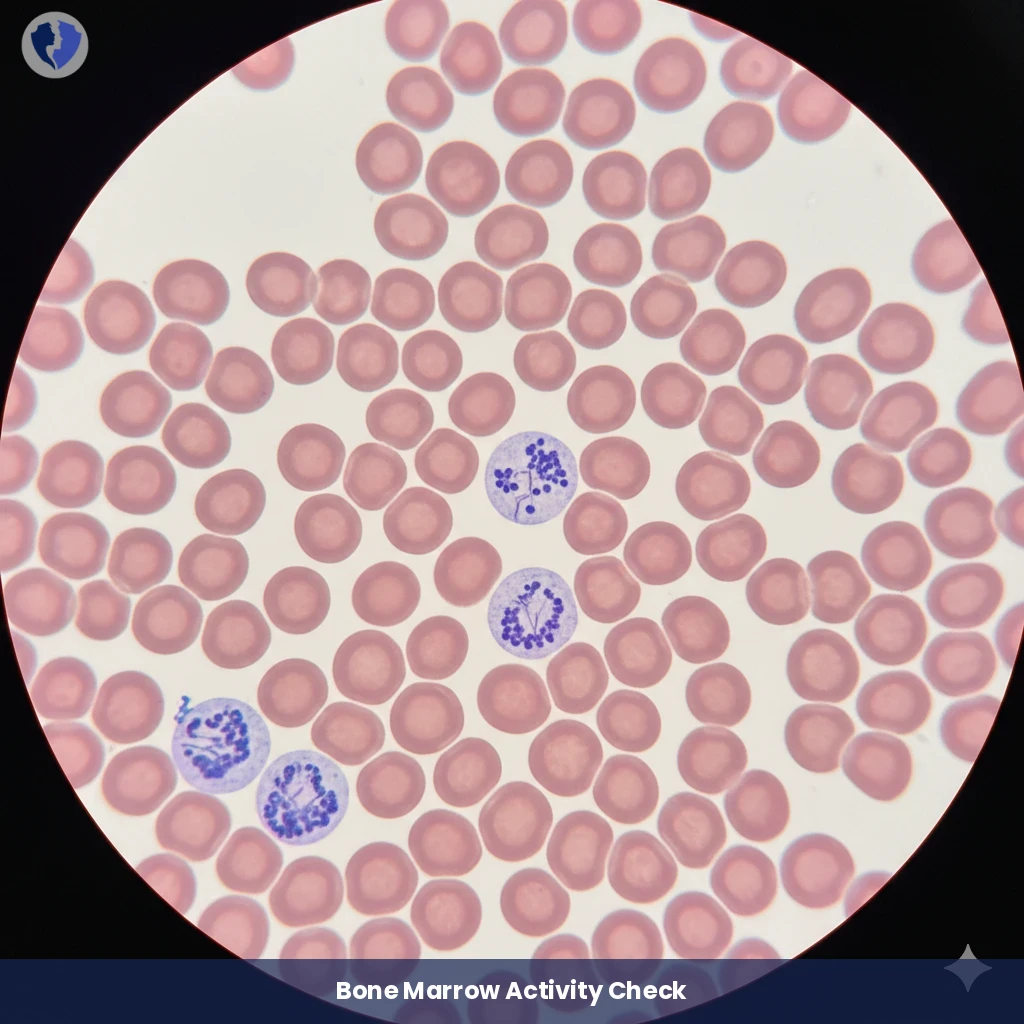
Reticulocyte Count Test

Service Details
Reticulocyte Count Test
A quantitative blood test measures the percentage or absolute number of reticulocytes in peripheral blood. Reticulocytes are immature, newly produced red blood cells released from the bone marrow into the bloodstream before losing their nuclei and retaining remnants of organelles (a network of RNA and ribosomes) that can be stained and numbered microscopically or using automated hematological analyzers. The reticulocyte percentage reflects the activity of red blood cell production in the bone marrow (erythropoiesis).